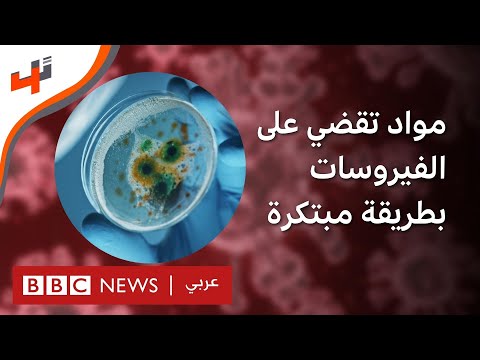
YouTube video

Peptide BioNanomaterials Group
130 posts


@PBN_Group
In Peptide BioNanomaterials Group (PBNG), we design short self-assembling peptides for the fabrication of biomaterials.










Please check out our recent paper led by @CosLigorio and Soraya on a biocooperative approach to turn whole blood into personalised and tuneable regenerative implants @iskratsch @ERC_Research @AOCMF_BOOST @NottmBRCMSIR @UoN_BDI @UoN_RMCT onlinelibrary.wiley.com/doi/10.1002/ad…

📢 PhD position available in my lab! We are interested in developing host-targeting antivirals against coronaviruses & emerging viruses. Join our multidisciplinary and supportive team, w/ @t_snape. Fully-funded for UK students. Deadline 26 July. findaphd.com/phds/project/d…









Microfluidic-Assisted Biofabrication twitter.com/i/broadcasts/1…

Early career setbacks make you stronger! nature.com/articles/s4146…
